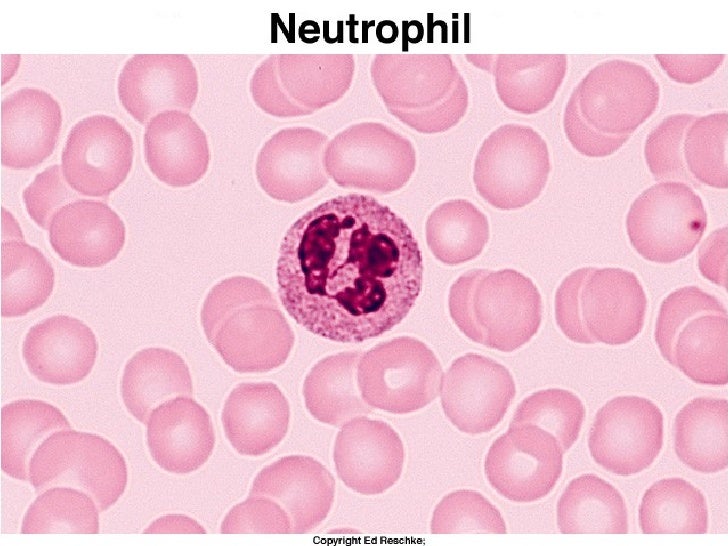

Палочкоядерные клетки, или нейтрофилы, являются ключевыми компонентами иммунной системы организма, специализирующимися на борьбе с бактериальными и грибковыми инфекциями. Эти клетки характеризуются своим специфическим видом ядра, которое состоит из нескольких сегментов, что и дало им название. В процессе эволюции нейтрофилы развили уникальные механизмы защиты, включая фагоцитоз, то есть способность поглощать и переваривать патогены, а также выделять мощные противомикробные вещества. Рассмотрим подробнее структуру, функции и роль палочкоядерных клеток в поддержании здоровья организма.
Палочкоядерные клетки